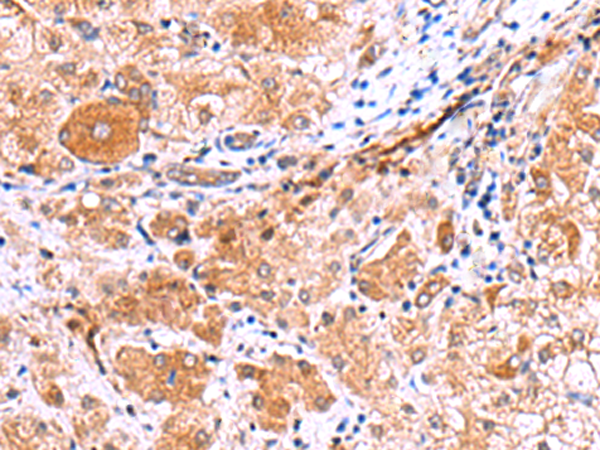
一抗

相關(guān)類別: 一抗
技術(shù)規(guī)格
Background:
Immunity-related GTPases (IRG) (also known as p47 GTPases) are a family of GTPase proteins found in vertebrates, which play critical roles in mediating innate resistance to intracellular pathogens. IRG genes have been found in a number of mammals and lower species including mice, rats, zebrafish and humans. Most of the mouse genes contain interferon-stimulated response elements which mediate transcriptional activation by IFNs. In humans, only two IRG genes have been found: human IRGC encodes a full-length IRG protein that, like the mouse homologue, is constitutively expressed in testis, while human IRGM encodes a considerably truncated protein that is constitutively expressed in cultured cells including some macrophage cell lines. As the two human genes IRGC and IRGM are not subject to IFN control, it has been suggested that the host resistance mechanism supported by IRG proteins in the mouse is lacking in humans.
Applications:
ELISA, IHC
Name of antibody:
IRGC
Immunogen:
Synthetic peptide of human IRGC
Full name:
immunity related GTPase cinema
Synonyms:
IFGGE; IRGC1; Iigp5; CINEMA; R30953_1
SwissProt:
Q6NXR0
ELISA Recommended dilution:
5000-10000
IHC positive control:
Human liver cancer and Human thyroid cancer
IHC Recommend dilution:
30-150


 購物車
購物車 幫助
幫助
 021-54845833/15800441009
021-54845833/15800441009